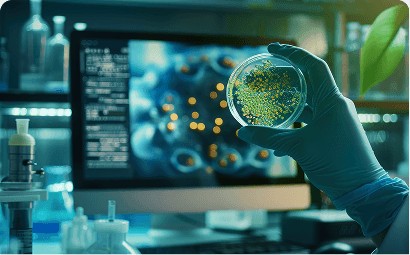
Biotech

Libérez le potentiel de votre entreprise grâce à l’IA
Nous intégrons les modèles d'IA générative & Agentique ainsi que les outils d'automatisation dans vos processus pour accélérer vos prises de décision et alléger vos tâches quotidiennes. Nos solutions s'adaptent à votre environnement — cloud privé, public ou hybride — pour une adoption fluide et sécurisée.